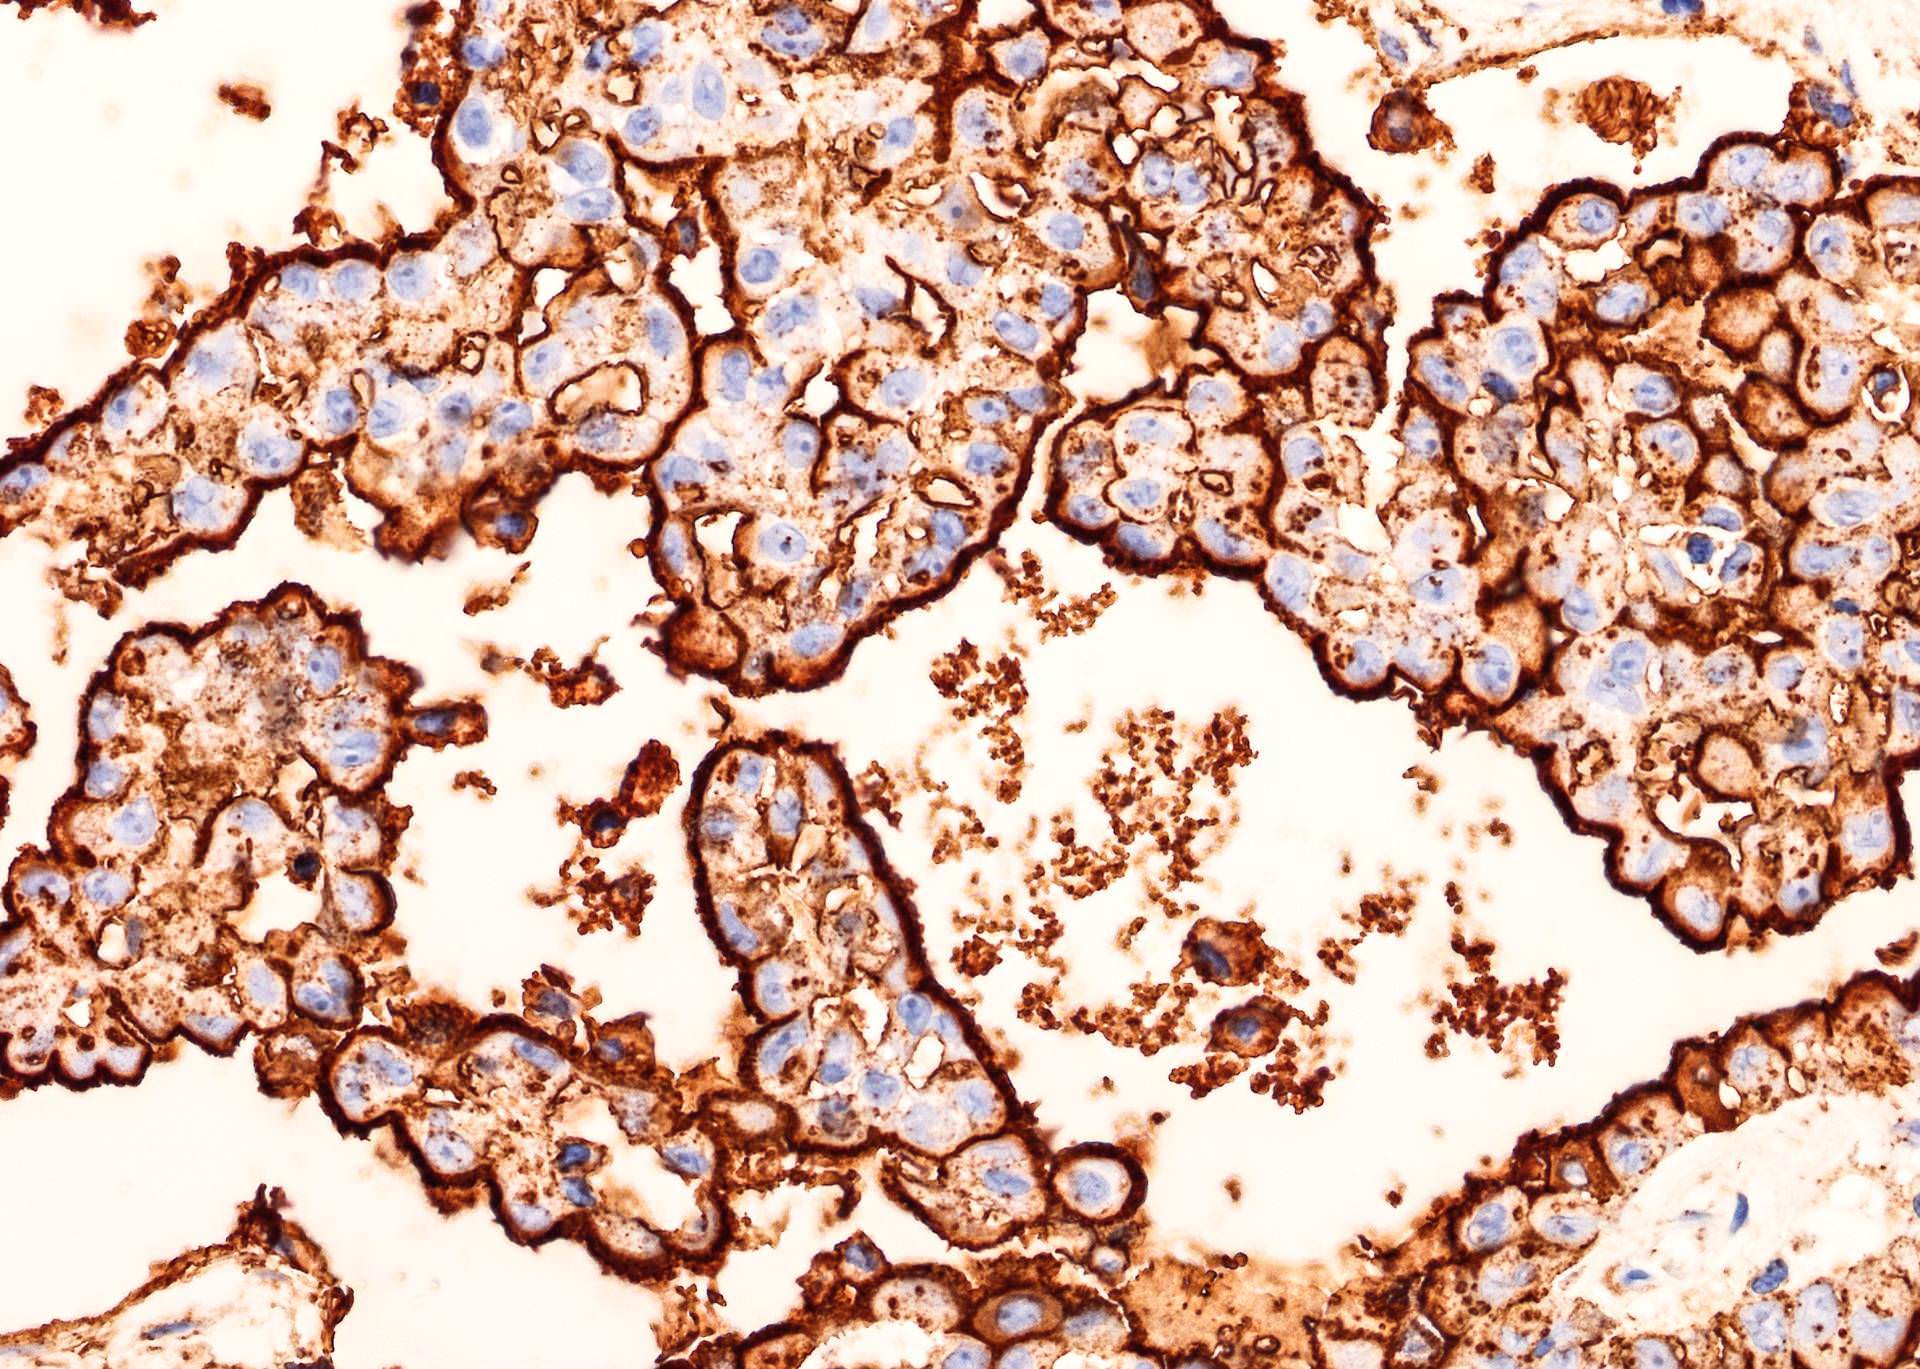

Stains & CD markers
HBME
Last author update: 1 June 2005
Last staff update: 25 August 2023
Copyright: 2003-2024, PathologyOutlines.com, Inc.
PubMed Search:
HBME
Page views in 2023: 8,645
Page views in 2024 to date: 2,396
Cite this page: Pernick N. HBME. PathologyOutlines.com website. https://www.pathologyoutlines.com/topic/stainshbme.html. Accessed April 17th, 2024.
Definition / general
- Also called HBME-1
- Marker of mesothelial cells, named after laboratory of Dr. Hector Battifora and MEsothelioma
- Also positive in various thyroid carcinomas
Microscopic (histologic) images
Contributed by Andrey Bychkov, M.D., Ph.D.

Tumor interface

Striking membranous staining

Strong membranous HBME-1 immunoreactivity

Strong HBME-1
immunoreactivity
with apical membrane
accentuation
Back to top